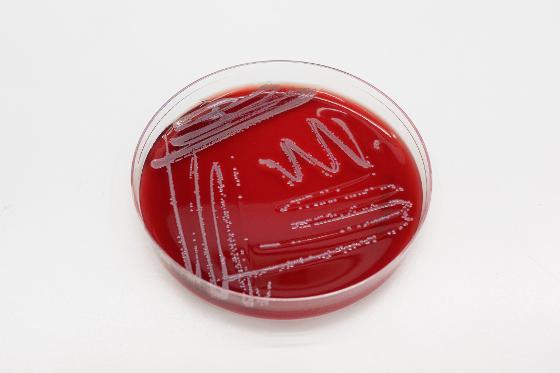
staphylococcus borealis_2000px-2.jpg

2020
Achten, N.B., Klingenberg, C., Plötz, F.B. (2020) Neonatal Early-Onset Sepsis Calculator and Antibiotic Therapy-Reply. JAMA Pediatr. 2020 May 1,174(5):508-509. doi:10.1001/jamapediatrics.2019.6269. PMID: 32150235
Dretvik, T., Solevåg, A.L., Finvåg, A., Størdal ,E.H., Størdal, K., Klingenberg, C. (2020) Active antibiotic discontinuation in suspected but not confirmed early-onset neonatal sepsis-A quality improvement initiative. Acta Paediatr. 2020 Jun,109(6):1125-1130. doi: 10.1111/apa.15202. Epub 2020 Feb 15. PMID: 31999863 https://doi.org/10.1111/apa.15202
Elvebakk, A., Park, S.G., Haeng, C., Rämä, T. (2020) Psoroma capense and P. esterhuyseniae (Pannariaceae), two new alpine species from South Africa. The Lichenologist 2020 ,Volum 52.(5) s. 345-352. https://doi.org/10.1017/S0024282920000377
Ezawa, T., Saito, R., Suzuki, S., Sugiyama, S., Sylte, I., Kurita, N. (2020) Protonation states of central amino acids in a zinc metalloprotease complexed with inhibitor: Molecular mechanics optimizations and ab initio molecular orbital calculations. Biophys Chem. 2020 Jun,261:106368. https://doi.org/10.1016/j.bpc.2020.106368
Ezawa ,T., Sugiyama, S., Ara, A., Sylte, I., Kurita, N. (2020) Design of galardine analogs as putative psudolysin inhibitors based on ab initiofragment molecular orbital calculations. J Biomol Struct Dyn. 2020 Jul,38(11):3307-3317. Epub 2019 Aug 29.PMID: 31422741 https://doi.org/10.1080/07391102.2019.1656672
Fellner, M., Lentz, C.S., Jamieson, S.A., Brewster, J.L., Chen, L., Bogyo, M., Mace, P.D. (2020) Structural Basis for the Inhibitor and Substrate Specificity of the Unique Fph Serine Hydrolases of Staphylococcus aureus. ACS Infect Dis. 2020 Oct 9,6(10):2771-2782. https://pubmed.ncbi.nlm.nih.gov/32865965/
Ferrand, R.A., McHugh, G., Rehman, A.M., Mujuru, H., Simms, V., Majonga, E.D., Nicol, M.P., Flaegstad, T., Gutteberg, T.J., Gonzalez-Martinez, C., Corbett, E.L., Rowland-Jones, S.L., Kranzer, K., Weiss, H.A., Odland, J.O., BREATHE Trial Group.(2020) Effect of Once-Weekly Azithromycin vs Placebo in Children With HIV-Associated Chronic Lung Disease: The BREATHE Randomized Clinical Trial. JAMA Netw Open. 2020 Dec 1,3(12):e2028484. https://doi.org/10.1001/jamanetworkopen.2020.28484
Flygel, T.T., Sovershaeva, E., Claassen-Weitz, S., Hjerde, E., Mwaikono, K,S., Odland, J.Ø., Ferrand, R.A., Mchugh, G., Gutteberg, T.J., Nicol, M.P., Cavanagh, J.P., Flægstad, T., BREATHE Study Team. (2020) Composition of Gut Microbiota of Children and Adolescents With Perinatal Human Immunodeficiency Virus Infection Taking Antiretroviral Therapy in Zimbabwe. J Infect Dis. 2020 Jan 14,221(3):483-492. https://doi.org/10.1093/infdis/jiz473
Fröhlich, C., Gama, J.A., Harms, K., Hirvonen ,V.H.A., Lund, B.A., van der Kamp, M.W., Johnsen, P.J., Samuelsen, Ø.,Leiros H.-K.S. (2020) Cryptic β-lactamase evolution is driven by low β-lactam concentrations. Submitted to Communications Biology, Jan 2021 https://doi.org/10.1101/2020.12.01.404343
Fröhlich, C., Sørum, V., Huber, S., Samuelsen, Ø., Berglund, F., Kristiansson, E., Kotsakis, S.D., Marathe, N.P., Larsson, D.G.J., Leiros, H.S.(2020) Structural and biochemical characterization of the environmental MBLs MYO-1, ECV-1 and SHD-1. J Antimicrob Chemother. 1,75(9):2554-2563. https://doi.org/10.1093/jac/dkaa175.
Gama, J.A., Kloos, J., Johnsen, P.J., Samuelsen, Ø. (2020) Host dependent maintenance of a blaNDM-1-encoding plasmid in clinical Escherichia coli isolates. Sci Rep. 9,10(1):9332. https://doi.org/10.1038/s41598-020-66239-8
Gama, J.A., Zilhão, R., Dionisio, F. (2020). Plasmid Interactions Can Improve Plasmid Persistence in Bacterial Populations. Frontiers in Microbiology. https://doi.org/10.3389/fmicb.2020.02033
Gama, J.A., Fredheim, E.G.A., Cléon, F., Reis, A.M., Zilhão, R., Dionisio, F. (2020). Dominance Between Plasmids Determines the Extent of Biofilm Formation. Frontiers in Microbiology. https://doi.org/10.3389/fmicb.2020.02070
Giordani, B., Basnet, P., Mishchenko, E., Luppi, B., Skalko-Basnet, N. (2020). Utilizing liposomal quercetin and gallic acid in localized treatment of vaginal Candida infections. Pharmaceutics 2020, Volum 12:9.(1) s. 1-21, https://doi.org/10.3390/pharmaceutics12010009
Goll, R., Johnsen, P.H., Hjerde, E., Diab, J., Valle, P.C., Hilpusch, F., Cavanagh, J.P. (2020) Effects of fecal microbiota transplantation in subjects with irritable bowel syndrome are mirrored by changes in gut microbiome. Gut Microbes. 2020 Nov 9,12(1):1794263. https://doi.org/10.1080/19490976.2020.1794263
Götzinger, F., Santiago-García, B., Noguera-Julián, A., Lanaspa, M., Lancella, L., Calò Carducci, F.I., Gabrovska, N., Velizarova, S., Prunk, P., Osterman, V., Krivec, U., Lo Vecchio, A., Shingadia, D., Soriano-Arandes, A., Melendo, S., Lanari, M., Pierantoni, L., Wagner, N., L'Huillier, A.G., Heininger, U., Ritz, N., Bandi, S., Krajcar, N,, Roglić, S., Santos, M., Christiaens, C., Creuven, M., Buonsenso, D., Welch, S.B., Bogyi, M,, Brinkmann, F., Tebruegge, M., ptbnet COVID-19 Study Group (Klingenberg C) (2020). COVID-19 in children and adolescents in Europe: a multinational, multicentre cohort study. Lancet Child Adolesc Health. 2020 Sep,4(9):653-661 https://doi.org/10.1016/S2352-4642(20)30177-2
Hagestad, O.C., Andersen, J.H., Altermark, B., Hansen, E., Rämä, T. (2020) Cultivable marine fungi from the Arctic Archipelago of Svalbard and their antibacterial activity. Mycology: An International Journal on Fungal Biology 2020, volume 11. (3). https://doi.org/10.1080/21501203.2019.1708492
Hansen, K.Ø., Hansen, I.K.Ø., Richard, C.S.M., Jenssen, M., Andersen, J.H., Hansen, Holst, E. (2020). Antimicrobial Activity of Securamines From the Bryozoan Securiflustra securifrons. Natural Product Communications 2021, Volum 16 (2). ISSN 1934-578X.s 1 - 8.s https://doi.org/10.3390/ijms21155460.
Hansen, I.K.Ø., Lövdahl, T., Simonovic, D., Hansen, K.Ø., Andersen, A.J.C., Devold, H., Richard, C.S.M. Andersen, J.H., Strøm, M.B. & Haug, T. (2020). Antimicrobial activity of small synthetic peptides based on the marine peptide turgencin A: prediction of antimicrobial peptide sequences in a natural peptide and strategy for optimization of potency. International Journal of Molecular Sciences, 21(15): 5460. https://doi.org/10.3390/ijms21155460.
Hansen, I.K.Ø, Isaksson, J., Poth, A.G., Hansen, K.Ø., Andersen, A.J.C., Richard, C.S., Blencke, H.M., Stensvåg, K., Craik, D.J. & Haug, T. (2020). Isolation and characterization of antimicrobial peptides with unusual disulfide connectivity from the colonial ascidian Synoicum turgens. Marine Drugs, 18(1):51. https://doi.org/10.3390/md18010051.
Hegstad, K., Mylvaganam, H., Janice, J.J., Josefsen, E., Sivertsen, A., Skaare, D. (2020). The role of horizontal gene transfer in the development of multidrug resistance in Haemophilus influenzae. mSphere 5:e00969-19. https://doi.org/10.1128/ mSphere.00969-19.
Hemmingsen, D., Mikalsen, C., Hansen, A.R., Fjalstad, J.W., Stenklev, N.C., Klingenberg, C. (2020) Pediatrics. Hearing in Schoolchildren After Neonatal Exposure to a High-Dose Gentamicin Regimen. 2020 Feb,145(2):e20192373. Epub 2020 Jan 8. PMID: 31915192 https://doi.org/10.1542/peds.2019-2373
Hira, J., Bentdal, S., Devold, H., Stensvåg, K. & Landfald, B. (2019) Vibrio echinoideorum sp. nov., isolated from an epidermal lesion on the test of a green sea urchin (Strongylocentrotus droebachiensis). International Journal of Systematic and Evolutionary Microbiology, 69(8):2277–2282. https://doi.org/doi:10.1099/ijsem.0.003462.
Hira, J., Uddin, J., Haugland, M.M., Lentz, C.S. (2020)From Differential Stains to Next Generation Physiology: Chemical Probes to Visualize Bacterial Cell Structure and Physiology. Molecules. 2020 Nov, 25(21): 4949. https://www.ncbi.nlm.nih.gov/pmc/articles/PMC7663024/
Hira, J., Wolfson, D., Andersen, A.J.C., Haug, T. & Stensvåg, K. (2020). Autofluorescence mediated red spherulocyte sorting provides insights into the source of spinochromes in sea urchins. Scientific Reports, 10(1):1149 https://doi.org/http://dx.doi.org10.1038/s41598-019-57387-7.
Håkonsholm, F., Hetland, M.A.K., Svanevik, C.S., Sundsfjord, A. Lunestad, B.T., Marathe, N. P. (2020) Antibiotic Sensitivity Screening of Klebsiella spp. and Raoultella spp. Isolated from Marine Bivalve Molluscs Reveal Presence of CTX-M-Producing K. pneumoniae. Microorganisms. 2020 Dec, 8(12):1909. https://doi.org/10.3390/microorganisms8121909
Jensen, V.V.S., Furberg, A-S., Slotved, H.S., Bazhukova, T., Haldorsen, B., Caugant, D.A., Sundsfjord, A., Valentiner-Branth, P., Simonsen, G.S. (2020) Epidemiological and molecular characterization of Streptococcus pneumoniaecarriage strains in pre-school children in Arkhangelsk, northern European Russia, prior to the introduction of conjugate pneumococcal vaccines. BMC Infect Dis. 2020, 20: 279. Published online 2020 Apr 15 https://doi.org/10.1186/s12879-020-04998-5
Johansen, T.B., Astrup, E., Jore, S., Nilssen, H., Dahlberg, B.B., Klingenberg, C., Berg, A.S., Greve-Isdah, l.M. (2020) Infection prevention guidelines and considerations for paediatric risk groups when reopening primary schools during COVID-19 pandemic, Norway, April 2020.Euro Surveill. 2020 Jun,25(22):2000921. PMID: 32524956 https://doi.org/10.2807/1560-7917.ES.2020.25.22.2000921
Jøraholmen, M.W., Bhargava, A., Julin, K., Johannessen, M., Skalko-Basnet, N. (2020) The Antimicrobial Properties of Chitosan Can be Tailored by Formulation. Marine Drugs 2020 ,Volum 18., https://doi.org/10.3390/md18020096
Jøraholmen, M.W., Johannessen, M., Gravningen, K., Puolakkainen, M., Acharya, G., Basnet, P., Škalko-Basnet, N. (2020) Liposomes-In-Hydrogel Delivery System Enhances the Potential of Resveratrol in Combating Vaginal Chlamydia Infection Pharmaceutics. 2020 Dec, 12(12): 1203. Published online 2020 Dec 11. https://doi.org/10.3390/pharmaceutics12121203
Jøraholmen, M.W., Bhargava, A., Julin, K., Johannessen, M., Škalko-Basnet, N. (2020) The Antimicrobial Properties of Chitosan Can Be Tailored by Formulation Mar Drugs. 2020 Feb, 18(2): 96. Published online 2020 Jan 31. https://doi.org/10.3390/md18020096
Keller, L.J., Lentz, C.S., Chen, Y.E., Metivier, R.J., Weerapana, E., Fischbach, M.A., Bogyo, M. (2020) Characterization of Serine Hydrolases Across Clinical Isolates of Commensal Skin Bacteria Staphylococcus epidermidisUsing Activity-Based Protein Profiling. ACS Infect Dis. 2020 May 8,6(5):930-938. https://doi.org/10.1021/acsinfecdis.0c00095
Klingenberg, C. (2020) Risk of bias in study on early antibiotics and necrotizing enterocolitis.J Pediatr. 2020 Jul 3:S0022-3476(20)30847-7. dOnline ahead of print. PMID: 32629011 https://doi.org/10.1016/j.jpeds.2020.07.004
Kunttu, P., Pasanen, H., Rämä, T., Kulju, M., Kunttu, S-A., Kotiranta, H. (2020). Diversity and ecology of aphyllophoroid fungi on driftwood logs on the shores of the Baltic Sea. Nordic Journal of Botany (NJB) 2020 Volum 38.(4). https://doi.org/10.1111/njb.02735
Lang, A., Klingenberg, C., Greve-Isdahl, M., Andresen, J.H. (2020) Neonates should be with their mothers, even if the mother has COVID-19. Tidsskr Nor Laegeforen. 2020 Mar 26,140(6). doi: 10.4045/tidsskr.20.0242. Print 2020 Apr 21. PMID: 32321214
Lavizzari, A., Klingenberg, C., Profit, J., Zupancic, J.A.F., Davis, A.S., Mosca, F., Bearer, C.F., Roehr, C.C. (2020) Neonates in the COVID-19 pandemic. Molloy International Neonatal COVID-19 Consortium. Pediatr Res. 2020 Aug 3Online ahead of print. PMID: 32746446 doi: 10.4045/tidsskr.20.0242
Lavizzari, A., Klingenberg, C., Profit, J., Zupancic, J.A.F., Davis, A.S., Mosca, F., Molloy, E.J., Roehr, C.C. (2020)International comparison of guidelines for managing neonates at the early phase of the SARS-CoV-2 pandemic. International Neonatal COVID-19 Consortium. Pediatr Res. 2020 Jun 15. Online ahead of print. PMID: 32541844 https://doi.org/10.1038/s41390-020-0976-5
Leiros, H-K.S., Thomassen, A.M.,Samuelsen, Ø., Flach, C.F., Kotsakis, S.D., Larsson, D.G.J. (2020). Structural insights in to the enhanced carbapenemase efficiency of OXA-655 compared to OXA-10. FEBS Open Bio. 10(9):1821-1832. https://doi.org/10.1002/2211-5463.12935. Epub 2020 Aug 8.
Pain, M., Wolden, R., Jaén-Luchoro, D., Salvà-Serra, F., Iglesias, B.P., Karlsson, R., Klingenberg, C., Cavanagh, J.P. (2020)Staphylococcus borealis sp. nov., isolated from human skin and blood. Int J Syst Evol Microbiol. 2020 Dec,70(12):6067-6078. https://doi.org/10.1099/ijsem.0.004499
Paulsen, M.H., Ausbacher, D., Bayer, A., Engquist, M., Hansen, T., Haug, T., Anderssen, T., Andersen, J.H., Ericson Sollid, J.U. & Strøm, M.B. (2019). Antimicrobial activity of amphipathic α,α-disubstituted β-amino amide derivatives against ESBL – CARBA producing multi-resistant bacteria, effect of halogenation, lipophilicity and cationic character. European Journal of Medicinal Chemistry, 183:111671-111682. https://doi.org/10.1016/j.ejmech.2019.111671
Pedersen, T., Tellevik, M.G., Kommedal, Ø., Lindemann, P.C., Moyo, S.J., Janice, J., Blomberg, B., Samuelsen, Ø., Langeland, N. (2020). Horizontal plasmid transfer among Klebsiella pneumoniaeisolates is the key factor for dissemination of extended-spectrum β-lactamases among children in Tanzania. mSphere 15,5(4):e00428-20. https://doi.org/10.1128/mSphere.00428-20
Pettersen, V.K., Arrieta, M.C. (2020) Host-microbiome intestinal interactions during early life: considerations for atopy and asthma development. Curr Opin Allergy Clin Immunol. 2020 Apr,20(2):138-148. doi: 10.1097/ACI.0000000000000629. PMID: 32004178
Rodríguez-Beltrán, J., Sørum, V., Toll-Riera, M., Vega, C. de la, Peña-Miller, R., Millán, Á.S. (2020) Genetic dominance governs the evolution and spread of mobile genetic elements in bacteria. Proc Natl Acad Sci. 2020 Jul 7,117(27):15755–62. https://doi.org/10.1073/pnas.2001240117
Rørtveit, G., Simonsen, G.S. (2020). The Primary Care Perspective on the Norwegian National Strategy against Antimicrobial Resistance. Antibiotics (Basel) 2020 Sep, 9(9): 622. https://doi.org/10.3390/antibiotics9090622
Samuelsen, Ø., Åstrand, O.A.H, Fröhlich, C., Heikal, A., Skagseth, S., Carlsen, T.J.O., Leiros, H-K.L., Bayer, A., Schnaars, C,, Kildahl-Andersen, G., Lauksund, S., Finke, S., Huber, S., Gjøen, T., Andresen, A.M.S., Økstad, O.A., Rongved, P. (2020) ZN148 – a modular synthetic metallo-β-lactamase inhibitor reverses carbapenem resistance in Gram-negative pathogens in vivo. Antimicrob Agents Chemother. 2020 May 21,64(6):e02415-19. https://doi.org/10.1128/AAC.02415-19. Print 2020 May 21.
Sanabria, A., Hjerde, E., Johannessen, M., Sollid, J.E., Simonsen, G.S., Hanssen, A-M. (2020). Shotgun-Metagenomics on Positive Blood Culture Bottles Inoculated With Prosthetic Joint Tissue: A Proof of Concept Study. Front Microbiol. 2020, 11: 1687. Published online 2020 Jul 17. https://doi.org/10.3389/fmicb.2020.01687
Schneider, Y. K-H., Jenssen, M., Isaksson, J., Østnes Hansen, K., Andersen, J.H., Hansen, E. (2020). Bioactivity of Serratiochelin A, a Siderophore Isolated from a Co-Culture of Serratia sp. and Shewanella sp.. Microorganisms 2020, Volum 8 (7). ISSN 2076-2607.s 1 - 17.s https://doi.org/10.3390/microorganisms8071042
Selvarajan, V., Obuobi, S.A.O, Pui, L., Rachel, E. (2020) Silica Nanoparticles—A Versatile Tool for the Treatment of Bacterial Infections. Frontiers in Chemistry 2020, Volum 8. (602)
Solstad, R.G., Johansen, C., Stensvåg, K., Strøm, M.B., Haug, T. (2020) Structure-activity relationship studies of shortened analogues of the antimicrobial peptide EeCentrocin 1 from the sea urchin Echinus esculentus. J. Pep. Sci. 2020,26:e3233. DOI:10.1002/psc.3233. https://doi.org/10.1002/psc.3233
Størdal, K., Bakken, I.J., Greve-Isdahl, M., Klingenberg, C., Helland, E., Nystad, W., Hjellvik, V., Gulseth, H.L. (2020) SARS-CoV-2 in children and adolescents in Norway: confirmed infection, hospitalisations and underlying conditions. Tidsskr Nor Laegeforen. 2020 Jun 24,140(11). doi: 10.4045/tidsskr.20.0457. Print 2020 Aug 18. PMID: 32815353
Ternullo, S., Schulte Werning, L., Holsæter, A.M., Skalko-Basnet, N. (2020). Curcumin-In-Deformable Liposomes-In-Chitosan Hydrogel as a Novel Wound Dressing. Pharmaceutics 2020 ,Volum 12.(1) https://doi.org/10.3390/pharmaceutics12010008
Thaulow, C.M., Lindemann, P.C., Klingenberg, C., Berild, D., Salvesen, B.H., Myklebust T.Å., Harthug, S. (2020) Epidemiology and Antimicrobial Susceptibility of Invasive Bacterial Infections in Children-A Population-Based Study From Norway. Pediatr Infect Dis J. 2020 Dec 24,Publish Ahead of Print. doi: 10.1097/INF.0000000000003013. Online ahead of print.PMID: 33298760
van Tilburg Bernardes, Pettersen, V.C., Gutierrez, M.W., Laforest-Lapointe, I., Jendzjowsky, N.G., Cavin, J-B., Vicentini, F.A., Keenan, C.M., Ramay, H.R., Samara, J., MacNaughton, W.K., Wilson, R.J.A., Kelly, M.M., McCoy,K.D., Sharkey, K.A., Arrieta, M-C. (2020) Intestinal fungi are causally implicated in microbiome assembly and immune development in mice Nat Commun. 2020, 11: 2577. Published online 2020 May 22. https://www.ncbi.nlm.nih.gov/pmc/articles/PMC7244730/
Vatne A, Klingenberg C, Øymar K, Rønnestad AE, Manzoni P, Rettedal S. Reduced Antibiotic Exposure by Serial Physical Examinations in Term Neonates at Risk of Early-onset Sepsis. Pediatr Infect Dis J. 2020 May,39(5):438-443. PMID: 32301920 https://doi.org/10.1097/INF.0000000000002590
Vimberg V, Cavanagh JP, Novotna M, Lenart J, Nguyen Thi Ngoc B, Vesela J, Pain M, Koberska M, Balikova Novotna G. Ribosome-Mediated Attenuation of vga(A) Expression Is Shaped by the Antibiotic Resistance Specificity of Vga(A) Protein Variants.Antimicrob Agents Chemother. 2020 Oct 20,64(11):e00666-20. Print 2020 Oct 20. PMID: 32816732 https://doi.org/10.1128/AAC.00666-20
Wirth, T., Bergot, M., Rasigade, J.P., Pichon, B., Barbier, M., Martins-Simoes, P., Jacob, L., Pike R., Tissieres, .P, Picaud JC, Kearns, A., Supply, P., Butin, M., Laurent, F., International Consortium for Staphylococcus capitis neonatal sepsis, ESGS Study Group of ESCMID (Klingenberg C) (2020) Niche specialization and spread of Staphylococcus capitis involved in neonatal sepsis. Nat Microbiol. 2020 May,5(5):735-745. Epub 2020 Apr 27. PMID: 32341568 https://doi.org/10.1038/s41564-020-0676-2
Wolden, R., Pain, M., Karlsson, R., Karlsson, A., Aarag Fredheim, E.G., Cavanagh, J.P. (2020) Identification of surface proteins in a clinical Staphylococcus haemolyticus isolate by bacterial surface shaving. BMC Microbiol. 2020 Apr 7,20(1):80. PMID: 3226483https://doi.org/10.1186/s12866-020-01778-8
Zykov, I.N., Frimodt-Møller, N., Småbrekke, L., Sundsfjord, A., Samuelsen, Ø. (2020) Efficacy of mecillinam against clinical multidrug-resistant Escherichia coli in a murine urinary tract infection model. 2020 Feb,55(2):105851. https://doi.org/10.1016/j.ijantimicag.2019.11.008.
2019
Achten NB, Klingenberg C, Benitz WE, Stocker M, Schlapbach LJ, Giannoni E, Bokelaar R, Driessen GJA, Brodin P, Uthaya S, van Rossum AMC, Plötz FB. Association of Use of the Neonatal Early-Onset Sepsis Calculator With Reduction in Antibiotic Therapy and Safety: A Systematic Review and Meta-analysis. JAMA Pediatr. 2019, 173(11):1032-1040
Agyepong N, Govinden U, Owusu-Ofori A, Amoako DG, Allam M, Janice J, Pedersen T, Sundsfjord A, Essack S. Genomic characterization of multidrug-resistant ESBL-producing Klebsiella pneumoniae isolated from a Ghanaian teaching hospital. Int J Infect Dis. 2019; 85:117123.
Cavanagh JP, Askarian F, Pain M, Bruun JA, Urbarova I, Wai SN, Schmidt F, Johannessen M. Proteome profiling of secreted and membrane vesicle associated proteins of an invasive and a commensal Staphylococcus haemolyticus isolate. Data Brief. 2019 Jan 11;22:914-919.
Granslo, Hildegunn Norbakken; Aarag, Elizabeth; Esaiassen, Eirin; Christophersen, Lars; Jensen, Peter Østrup; Mollnes, Tom Eirik; Moser, Claus; Flægstad, Trond; Klingenberg, Claus; Cavanagh, Jorunn Pauline. The synthetic antimicrobial peptide LTX21 induces inflammatory responses in a human whole blood model and a murine peritoneum model. Acta Pathologica, Microbiologica et Immunologica Scandinavica (APMIS) 2019 ;Volum 127.(6) s. 475483.
Hagestad, Ole Christian; Andersen, Jeanette hammer; Altermark, Bjørn; Hansen, Espen; Rämä, Teppo. Cultivable marine fungi from the Arctic Archipelago of Svalbard and their antibacterial activity. Mycology: An International Journal on Fungal Biology 2019.
Jarlier, Vincent; Högberg, Liselotte Diaz; Heuer, Ole E.; Campos, Josó; Eckmanns, Tim; Giske, Christian G.; Grundmann, Hajo; Johnson, Alan P.; Kahlmeter, Gunnar; Monen, Jos; Pantosti, Annalisa; Rossolini, Gian Maria; van de Sande-Bruinsma, Nienke; Vatopoulos, Alkiviadis; Żabicka, Dorota; Žemličková, Helena; Monnet, Dominique L.; Simonsen, Gunnar Skov. Strong correlation between the rates of intrinsically antibiotic-resistant species and the rates of acquired resistance in Gram-negative species causing bacteraemia, EU/EEA, 2016. Eurosurveillance 2019; Volum 24 (33). ISSN 1025-496X.s 1 - 10.
Jøraholmen, May Wenche; Basnet, Purusotam; Tostrup, Mia Jonine; Moueffaq, Sabrin; Skalko-Basnet, Natasa. Localized Therapy of Vaginal Infections and Inflammation: Liposomes-InHydrogel Delivery System for Polyphenols. Pharmaceutics 2019; Volum 11 (2). ISSN 1999-4923.s 1 - 19.s
Littmann J, Simonsen GS. Antimicrobial resistance is a super wicked problem. Tidsskr Nor Laegeforen. 2019 Oct 31;139(16).
Pain M, Hjerde E, Klingenberg C, Cavanagh JP. Comparative Genomic Analysis of Staphylococcus haemolyticus Reveals Key to Hospital Adaptation and Pathogenicity. Front Microbiol. 2019 Sep 10;10:2096.
Paulsen MH, Ausbacher D, Bayer A, Engqvist M, Hansen T, Haug T, Anderssen T, Andersen JH, Sollid, JUE, Strøm MB Antimicrobial activity of amphipathic α,α-disubstituted β-amino amide derivatives against ESBL–CARBA producing multi-resistant bacteria; effect of halogenation, lipophilicity and cationic character. European Journal of Medicinal Chemistry 2019 ;Volum 183. s. 111671-111682
Sanabria A, Røkeberg MEO, Johannessen M, Sollid JE, Simonsen GS, Hanssen AM. Culturing periprosthetic tissue in BacT/Alert® Virtuo blood culture system leads to improved and faster detection of prosthetic joint infections. BMC Infect Dis. 2019 Jul 10;19(1):607.
Solstad RG, Johansen C, Stensvåg K, Strøm MB, Haug T. Structure‐activity relationship studies of shortened analogues of the antimicrobial peptide EeCentrocin 1 from the sea urchin Echinus esculentus. Journal of Peptide Science 2019 ;Volum 26.(2),
Sovershaeva E, Kranzer K, Mchugh G, Bandason T, Majonga ED, Usmani OS, Rowland-Jones S, Gutteberg T, Flægstad T, Ferrand RA, Odland JØ. History of tuberculosis is associated with lower exhaled nitric oxide levels in HIV-infected children. AIDS. 2019 Sep 1;33(11):1711-1718.
Svendsen, J.S.M., Grant, T.M., Rennison, D., Brimble, M.A., Svenson, J., Very Short and Stable Lactoferricin-Derived Antimicrobial Peptides: Design Principles and Potential Uses , Accounts of Chemical Research 2019, 52, 3, 749-759
Syre, Heidi; Hetland, Marit; Bernhoff, Eva; Bollestad, Marianne; Grude, Nils; Simonsen, Gunnar Skov; Löhr, Iren Høyland. Microbial risk factors for treatment failure of pivmecillinam in community‐acquired urinary tract infections caused by ESBL‐producing Escherichia coli. Acta Pathologica, Microbiologica et Immunologica Scandinavica (APMIS) 2019. ISSN 0903-4641.s 1 - 10.s
Ternullo, Selenia; Gagnat, Eivind; Julin, Kjersti; Johannessen, Mona; Basnet, Purusotam; Vanić, Željka; Skalko-Basnet, Natasa. Liposomes augment biological benefits of curcumin for multitargeted skin therapy. European journal of pharmaceutics and biopharmaceutics 2019; Volum 144. ISSN 0939-6411.s 154 - 164.s
Vanic, Zeljka; Rukavina, Zora; Manner, Suvi; Fallarero, Adyary; Uzelac, Lidija; Kralj, Marijeta; Amidzic Klaric, Danijela; Bogdanov, Anita; Raffai, Timea; Virok, Deszo Peter; Filipovic-Grcic, Jelena; Skalko-Basnet, Natasa. Azithromycin-liposomes as a novel approach for localized therapy of cervicovaginal bacterial infections. International Journal of Nanomedicine 2019; Volum 14. ISSN 1176-9114.s 5957 - 5976.s
Lenke til nyhet
.jpg)